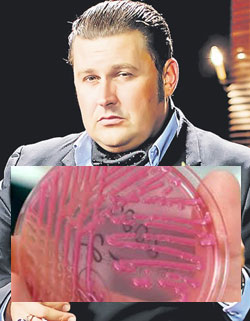

Mistificarea din spatele vaccinării. Cazul Toni Tecuceanu – oamenii manipulați de către autorități și mass-media să se vaccineze preventiv! (I)
Autoritățile și mass-media au mințit că Toni Tecuceanu a murit din cauza gripei porcine!
 În februarie 2014 a apărut un scandal monstru care s-a prelungit până în martie 2014, neputând fi aplanat oricât de mult au încercat cei de la Institutul Cantacuzino să o facă. Practic, vaccinurile antigripale pregătite pentru oameni aveau un nivel ridicat al endotoxinelor, încât s-a ajuns la concluzia că acestea produc şoc anafilactic şi reacţii adverse care duc la moartea pacientului.
În februarie 2014 a apărut un scandal monstru care s-a prelungit până în martie 2014, neputând fi aplanat oricât de mult au încercat cei de la Institutul Cantacuzino să o facă. Practic, vaccinurile antigripale pregătite pentru oameni aveau un nivel ridicat al endotoxinelor, încât s-a ajuns la concluzia că acestea produc şoc anafilactic şi reacţii adverse care duc la moartea pacientului.
În acest caz incredibil, unic în România, a fost implicat şi Serviciul Roman de Informaţii, fiind considerat „un caz periculos pentru siguranţa naţională”.
Cazul actorului român Toni Tecuceanu, sau cum au fost păcăliţi mii de români să se vaccineze!
La data de 5 decembrie 2010, actorul de comedie Toni Tecuceanu a murit la spitalul Matei Balş din Bucureşti, după ce întreaga mass-media masonică din România, alături de mulţi medici spuneau că „este o victimă a gripei porcine şi că trebuie să ne vaccinăm”.
La scurt timp, pe 9 februarie 2010, s-a stabilit și cauza datorită căreia a murit Tecuceanu.
Hai să vedem cât de „bolnav” de „gripă porcină” era el
De pe site-ul de ştiri realitatea.net aflăm că pe data de 9 februarie 2010, la aproape două luni de la moartea sa, familia a primit verdictul medical şi de vină nu a fost gripa porcină, ci o bacterie acinetobacter, contractată dintr-un aparat de ventilaţie de la secţia de Terapie Intensivă:
De pe site-ul de ştiri realitatea.net aflăm că pe data de 9 februarie 2010, la aproape două luni de la moartea sa, familia a primit verdictul medical şi de vină nu a fost gripa porcină, ci o bacterie acinetobacter, contractată dintr-un aparat de ventilaţie de la secţia de Terapie Intensivă:
„În certificatul medico-legal este confirmat gripă A/H1N1, dar printre altele şi faptul că fratele meu a luat de la aparate acinetobacter. E vorba de o bacterie, nu ştiu cât de puternică este ea, nu ştiu nici dacă ea este cea care până la urmă a cauzat decesul, dar este clar că afirmaţiile pe care eu le-am făcut când am spus că fratele meu a luat ceva de la aparate, eu ştiam de un virus, mă rog, s-a demonstrat că e o bacterie… până la urmă eu am spus adevărul” a declarat Paul Tecuceanu, fratele actorului.
El a spus că îşi doreşte ca cei din spital să plătească pentru fapta lor. „Urmează să mă văd cu un avocat. Apoi voi şti dacă merg sau nu mai departe”, a declarat Paul Tecuceanu, citat de ediţia electronică a Adevărul.
Iniţial, medicii de la Institutul de Boli Infecţioase Matei Balş au refuzat eliberarea dosarului medical al actorului către familia acestuia. La vremea respectivă, doctorul Adrian Streinu Cercel, secretar de stat în Ministerul Sănătăţii, a motivat refuzul prin faptul că actele reprezintă documente medico-legale şi, în conformitate cu Legea privind drepturile pacientului, acestea nu pot fi eliberate decât la solicitarea expresă a organelor abilitate.
Redăm în continuare articolul prezentat de către jurnaliştii de la cotidianul Curentul.ro, care expune pe larg manipularea ordinară a presei şi a medicilor pentru a se vinde vaccinurile:
„Ieri o instanță românească a dat dreptate familiei unui îndrăgit actor, Toni Tecuceanu, decedat în Spitalul Matei Balș, în condiții misterioase. Familiei i s-a interzis abuziv și ilegal accesul la dosarul medical al lui Toni. Dosar medical secretizat printr-o decizie aberantă a directorului spitalului, Streinu Cercel.
Tribunalul București a admis cererea prin care fratele și tatăl lui Toni Tecuceanu cereau eliberarea dosarului medical complet al lui Toni și «obligă pârâtul Institutul Național de Boli Infecțioase Prof. Dr. Matei Balș la comunicarea dosarului medical complet al defunctului Tecuceanu Aurelian Antonio».
În data de 5 ianuarie 2010 tânărul și îndrăgitul actor Toni Tecuceanu a murit în spitalul Matei Balș. S-a pretins că Toni Tecuceanu a murit de virusul gripei porcine și moartea sa a declanșat o adevărată isterie mediatică. Controversatul vaccin al așa-zisului virus era o prioritate pentru Ministerul Sănătății și un mare business pentru niște companii farmaceutice.
Toni Tecuceanu nu a murit de «gripă porcină» ci de un virus contractat în spitalul lui Streinu Cercel, care a folosit apoi moartea tânărului actor pentru a declanșa isteria vaccinării populației, o operațiune care ar fi trebuit să facă obiectul unei anchete a autorităților statului.
Acum se știu destule date pentru a avea o imagine mai clară asupra celor două isterii lansate la nivel mondial, despre gripa porcină și gripa aviară, pentru a înțelege că la mijloc s-a aflat un uriaș business dar și o acțiune de înspăimântare a populației. În România au fost ucise sute de mii de păsări iar tema gripelor misterioase a dispărut cum a venit, fără urme.
Manipulare cinică a opiniei publice pentru vânzarea vaccinurilor
 Adunarea parlamentară a Consiliului Europei a pus sub anchetă implicarea firmelor farmaceutice în „promovarea” gripei porcine. La noi, capii sistemului medical implicați în manipularea opiniei publice și distribuirea vaccinurilor au lansat tot felul de scenarii catastrofice, iar pentru a accentua tema au înscenat și alte «spectacole» macabre.
Adunarea parlamentară a Consiliului Europei a pus sub anchetă implicarea firmelor farmaceutice în „promovarea” gripei porcine. La noi, capii sistemului medical implicați în manipularea opiniei publice și distribuirea vaccinurilor au lansat tot felul de scenarii catastrofice, iar pentru a accentua tema au înscenat și alte «spectacole» macabre.
Adrian Streinu Cercel, în calitate de secretar de stat în Ministerul Sănătății, a declarat la o televiziune de mare audiență, mințind cu nerușinare, că: «Toni Tecuceanu a murit de gripă porcină. Pe foaia de observație scrie clar că a fost gripă nouă. Virusul AH1N1 a fost identificat și confirmat». Ulterior, deși fratele actorului, Paul Tecuceanu, a solicitat această foaie de observație, Streinu Cercel a refuzat să acorde o copiei familiei invocând «drepturile pacientului». Ale pacientului mort în spitalul său.
Moartea lui Toni Tecuceanu, o vedetă tv, personaj bine cunoscut publicului românesc, a fost utilizată cinic pentru a băga frica în români. Moartea sa a fost suspectă însă din cu totul alte motive. Toni Tecuceanu a fost îmbolnăvit în spital, iar apoi dosarul său medical a fost secretizat. Printr-o decizie incredibilă, familiei i s-a interzis după moartea actorului accesul la dosar.
Demență, ticăloșie sau ambele la un loc, cert este că abia după trei ani de procese, de nesfârșite termene și amânări în instanțele românești, lente în anumite cazuri, s-a obținut după o adevărată bătălie juridică accesul familiei la dosar. Este meritul cunoscutului avocat Iulian Urban, la vremea aceea senator, care a cerut schimbarea legii sănătății, în care era inclus acel aberant pasaj de care s-a prevalat Streinu Cercel pentru a afirma că doar mortul poate să-și vadă dosarul medical – familia nu!!!
Durerea unui frate
Cităm din mărturia lui Paul Tecuceanu, fratele lui Toni: «Decesul fratelui meu este încă învăluit în mister. Deși am încercat să obțin pe cale amiabilă o copie a dosarului medical complet al lui Toni, managerul Institutului Național de Boli Infecțioase Prof. Dr. Matei Balș, profesor doctor Adrian Streinu Cercel, a refuzat să mi-o acorde invocând prevederile legii numărul 46/2003, privind drepturile pacientului.
Șocat de răspunsul primit din partea acestuia, am decis să caut dreptatea în instanță. Astfel, împreună cu tatăl meu, Tecuceanu Ioan, am depus o acțiune prin care am chemat în judecată Institutul Național de Boli Infecțioase Prof. Dr. Matei Balș și pe profesorul Adrian Streinu Cercel. Considerăm că managerul Institutului Național de Boli Infecțioase Prof. Dr. Matei Balș a încălcat chiar el prevederile legii numărul 46/2003, privind drepturile pacientului, atunci când a vorbit în presă despre diagnosticul și cauza morții lui Toni, fără să aibă în prealabil acordul scris al acestuia sau al familiei.»
În data de 08 aprilie 2010, ora 14:30, la Judecătoria Sectorului 2 din București, a început o îndelungată bătălie juridică, debutul procesului intentat de familia lui Toni Tecuceanu lui Adrian Streinu Cercel și Institutului Național de Boli Infecțioase „Profesor Doctor Matei Balș” din Capitală, în cazul morții îndrăgitului actor.
O victorie, după trei ani de procese
 Fratele și tatăl lui Toni au câștigat pentru a doua oară în instanță dreptul de a vedea actele medicale. Primul succes a fost înregistrat tot la Tribunalul București, la data de 07.12.2011. Spitalul condus de Adrian Streinu Cercel a făcut însă recurs, iar în iunie 2012, Curtea de Apel București, spre rușinea ei, a casat sentința și a trimis dosarul la rejudecare.
Fratele și tatăl lui Toni au câștigat pentru a doua oară în instanță dreptul de a vedea actele medicale. Primul succes a fost înregistrat tot la Tribunalul București, la data de 07.12.2011. Spitalul condus de Adrian Streinu Cercel a făcut însă recurs, iar în iunie 2012, Curtea de Apel București, spre rușinea ei, a casat sentința și a trimis dosarul la rejudecare.
Paul Tecuceanu scrie: «E dreptul nostru să știm de ce a murit fratele meu. Mai mult, acest caz este unul special. Spitalul, prin vocea domnului Streinu Cercel, a oferit unor terți date din dosarul medical al lui Toni, fără să aibă acordul său sau al familiei. Apoi, ne-a refuzat nouă accesul la dosarul medical, argumentând această decizie prin faptul că art. 21 din Legea 46/2003 nu le permite acest lucru. Ori, să susții așa ceva este aberant! Cum să invoci un articol de lege pe care chiar tu l-ai încălcat, iar apoi să te folosești de el fără nicio remușcare? Sunt convins că vom afla lucruri interesante din acest dosar medical.
În plus, sper ca măcar acum, în al 12-lea ceas, conducerea de la Matei Balș să dea dovadă de bun simț și să predea dosarul medical! Trebuie să-și recunoască înfrângerea! În orice caz, suntem pregătiți să învingem și la recurs! Justiția trebuie să-și facă datoria corect, până la capăt! Dreptatea este de partea noastră și ne vom lupta până la capăt pentru adevăr.»
Cu o zi înainte de sentință, Paul Tecuceanu îl invoca cu speranță pe Radu Gyr: «Înfrânt nu ești atunci când sângerezi/ Nici ochii când în lacrimi ți-s/ Adevăratele înfrângeri/ Sunt renunțările la vis!»… ”
Substanţele chimice extrem de toxice pe care le conţin vaccinurile!
Dacă evreul Henry Kissenger trasa încă din anul 1975 un plan perfect de reducere a populaţiei planetei prin chimicalizarea mâncării şi a băuturii prin ceea ce se numeşte acum Codex Alimentarius, intrat în vigoare oficial de la 31 decembrie 2009, Bil Gates, o altă tentaculă a așa-zișilor „iluminaţi”, nu s-a sfiit să declare în mod public că este nevoie de reducerea populaţiei planetei sub pretextul că aşa „am putea scăpa de încălzirea globală”, încălzire globală ce este ceva ciclic şi nu unic cum vor ei să ne facă să credem.
În cadrul unei conferinţe TED (Tehnologie, Entertainment, Design), miliardarul Microsoft Bill Gates a vorbit despre problema emisiilor de CO2. Pentru controlarea şi reducerea efectelor distrugătoare ale poluării asupra mediului, Gates a propus o modalitate matematică de aducere la zero a măcar unuia dintre factorii poluanţi.
Ecuația propusă de el arată astfel: CO2 = P x S x E x C, unde:
P = Persoane/locuitori ai globului
S = Servicii/persoană
E = energie/servicii
C = CO2/unitate de energie
Concluzia sa: „probabil unul din factorii acestei înmulțiri ar trebui să fie adus aproape de zero.”
Primul factor al ecuaţiei lui Bill Gates este reprezentat de populaţie, iar despre aceasta el afirmă: „Lumea de azi are 6,8 miliarde de oameni… cifră care va ajunge până la aproximativ 9 miliarde. Or, dacă facem o treabă foarte bună cu noile vaccinuri, cu serviciile medicale, cu serviciile de sănătate a reproducerii, am putea, cel mai probabil, să reducem acest număr cu 10 sau 15%.”
Reducerea populaţiei mondiale prin vaccinuri
 Bill Gates a făcut această declaraţie plină de „francheţe” fără a lăsa loc de ezitare sau interpretări. Din spusele sale reiese clar faptul că vaccinurile şi serviciile de sănătate sunt controlate la nivel mondial în scopul reducerii tacite, dar sigure a populaţiei lumii. Iar acest scop al elitelor care conduc lumea din umbră ar putea fi atins într-un mod care să treacă neobservat, cu efecte vizibile poate peste 10 – 30 de ani, prin accelerarea unor boli degenerative, dar și prin reducerea fertilităţii şi, prin urmare, a ratei natalităţii în întreaga lume. Astfel, populaţia lumii ar scădea dramatic pentru mai multe generaţii succesive.
Bill Gates a făcut această declaraţie plină de „francheţe” fără a lăsa loc de ezitare sau interpretări. Din spusele sale reiese clar faptul că vaccinurile şi serviciile de sănătate sunt controlate la nivel mondial în scopul reducerii tacite, dar sigure a populaţiei lumii. Iar acest scop al elitelor care conduc lumea din umbră ar putea fi atins într-un mod care să treacă neobservat, cu efecte vizibile poate peste 10 – 30 de ani, prin accelerarea unor boli degenerative, dar și prin reducerea fertilităţii şi, prin urmare, a ratei natalităţii în întreaga lume. Astfel, populaţia lumii ar scădea dramatic pentru mai multe generaţii succesive.
Metoda inducerii unei „morți lente” pare a fi preferată de oamenii de ştiinţă care pe de o parte doresc să vadă populaţia mondială în scădere, însă nu au destul curaj să ucidă oamenii direct, prin medicina convenţională.
Există deja dovezi că vaccinurile pot provoca avorturi spontane. De asemenea, vaccinurile ar putea fi folosite pentru a creşte rata de deces în cazul unei viitoare pandemii. În spatele eforturilor de vaccinare pe scară largă s-ar putea afla o portiță de eliberare intenționată a unei tulpini de gripă extrem de agresivă, cu o rată de mortalitate ridicată. Această abordare a vaccinurilor ca „arme biologice” ar putea duce la uciderea a milioane de oameni, al căror sistem imunitar a fost slăbit ca urmare a vaccinărilor realizate anterior. Pare a fi un scenariu de film, însă realitatea pe care o trăim confirmă presupunerile cele mai sumbre.
Fundaţia Bill şi Melinda Gates
Fundaţia Bill şi Melinda Gates a investit sute de milioane de dolari în programe de vaccinare destinate oamenilor din întreaga lume. Unul dintre aceste programe este destinat cercetării şi dezvoltării de „vaccinuri activate de transpiraţie”, fabricate din nano-materiale cu învelişuri speciale pentru a introduce vaccinurile în organismul uman fără a folosi injecţii. În plus, fundaţia sa a investit milioane de dolari în tehnologii de sterilizare care au fost numite soluţii de „castrare temporară”. Astfel, scopul său declarat, de reducere a populaţiei globale cu 10 până la 15%, ar putea fi atins în doar câţiva ani…
Nu întâmplător numele lui Gates s-a vehiculat când Guvernul Rwandei a anunţat că va controla rata natalităţii în ţară prin sterilizarea voluntară a bărbaţilor. Se preconiza ca până în 2015, unul din şapte ruandezi să devină infertil.
Programul e finanţat de Fondul HIV/SIDA al Organizaţiei Naţiunilor Unite. O instituţie despre care un alt magnat afirma că are soluţia pentru controlul demografic.
Bill Gates sau David Rockefeller nu sunt primii care militează pentru depopulare. Soţul reginei Elisabeta a II-a, Prinţul Philip, declara în august 1988 pentru Deutsche Press: „Dacă m-aş reîncarna, aş dori să revin pe pământ ca un virus ucigaş care să reducă populaţia umană.”
 Teoria infectării intenţionate a populaţiei cu un virus distrugător a provocat mişcări de masă în anii ’80 după descoperirea virusului HIV. A luat din nou avânt după ce moartea unui număr mare de oameni a fost asociată cu boli ca gripa aviară, gripă porcină sau boala vacii nebune.
Teoria infectării intenţionate a populaţiei cu un virus distrugător a provocat mişcări de masă în anii ’80 după descoperirea virusului HIV. A luat din nou avânt după ce moartea unui număr mare de oameni a fost asociată cu boli ca gripa aviară, gripă porcină sau boala vacii nebune.
În aprilie 2013, Peter Brabeck, şeful corporaţiei criminale Nestle (cu produsele căreia destui oameni se otrăvesc zilnic) a declarat că: „apa nu este un drept al omului şi că produsele naturiste nu sunt deloc bune”. Bineînţeles că aceste afirmaţii au scandalizat majoritatea oamenilor care le-au aflat, şi la scurt timp respectiva înregistrare a fost scoasă de pe YouTube. Dar a fost prea târziu, pentru că oamenii deja salvaseră acel clip, astfel că el există în continuare și acest ticălos nu mai poate nega.
Citiţi a doua parte a articolului.
Citiți și:
Nanoparticule mortale în vaccinul împotriva gripei porcine
11 ingrediente toxice care provoacă boli și care se găsesc în vaccinuri
După Vaxxed, un alt documentar despre vaccinuri, Man Made Epidemic, produs în Germania, a fost interzis în urma presiunilor Big Pharma
yogaesoteric
18 februarie 2017
